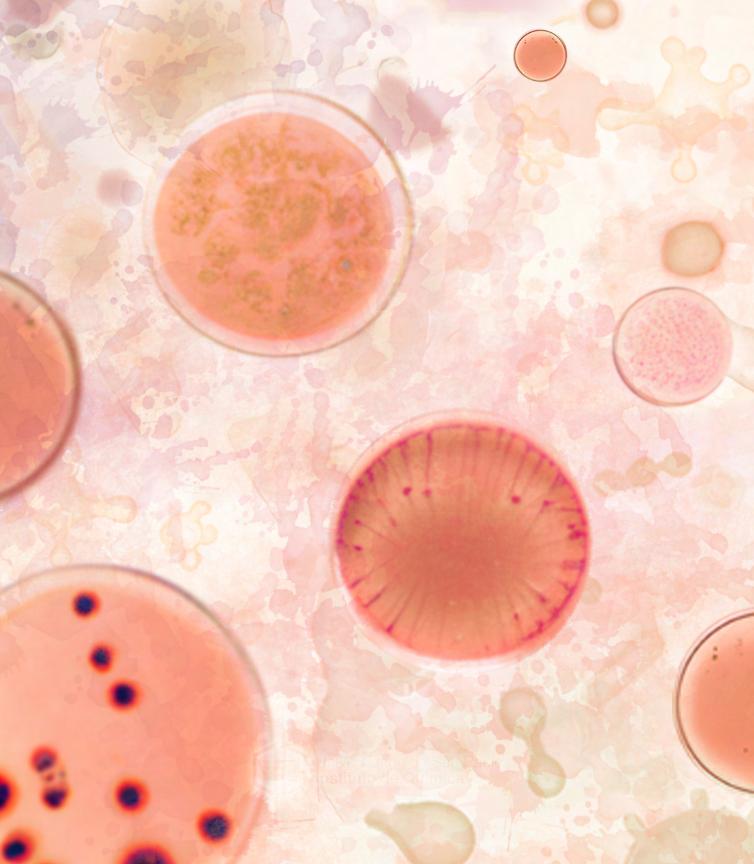

A revista do IQUSP







O Alquimista é um patrimônio do IQUSP. Publicado mensalmente desde 2005, ele nasceu da vontade de se ter um registro permanente de todos os acontecimentos e feitos memoráveis de nossa Instituição. Assim, nossa história ficaria para sempre à disposição das novas gerações de alunos, docentes e funcionários do IQ.
O responsável por assumir esta nobre missão foi o Prof. Dr. Hermi F. Brito — que segue conosco como editor chefe da revista. Hoje, além dele e dos colaboradores que já passaram por esta publicação, nós também assumimos o compromisso de registrar, divulgar e perpetuar todo o conhecimento produzido por nossa comunidade.
Assim, esperamos que gostem do resultado!
Equipe de Comunicação do IQUSP
UNIVERSIDADE DE SÃO PAULO Instituto de Química
Reitor
Prof. Dr. Carlos Gilberto Carlotti Junior
Pró-Reitora de Cultura e Extensão
Profª Drª Marli Quadros Leite
Diretor
Prof. Dr. Pedro Vitoriano de Oliveira
Vice-Diretor
Prof. Dr. Shaker Chuck Farah
Chefe do DQF
Prof. Dr. Massuo Jorge Kato
Chefe do DBQ
Prof. Dr. João Carlos Setubal
Editores
Prof. Dr. Hermi F. Brito
Bruna Larotonda Telezynski Lopes
Redação
Bruna Larotonda Telezynski Lopes
Aldrey Olegario
Projeto gráfico

Daniel Kniss
Lara Ribeiro Gianini
Colaborador
Cezar Guizzo
Mobilidade e formação de biofilmes: um caso de resistência bacteriana
Aplicabilidade de óleos essenciais extraídos da Mata Atlântica Paulista
Paulo Marques: Um rebelde por muitas causas
HU: o átomo que forma as Moléculas da Mudança
Relembramos alguns feitos da nossa comunidade entre 2020 e 2021
As principais publicações recentes sobre o Instituto de Química da USP
Paolo di Mascio: Entre arte e lembranças
A equipe nos bastidores do Alqumista
Exposição de produções artísticas produzidas por nossa comunidade

Bactérias são microrganismos conhecidos por sua capacidade de ocupar os mais diversos substratos terrestres — sejam eles o solo, a água, outros seres vivos e até nós, seres humanos. A maioria das espécies bacterianas não representa um risco à saúde — algumas delas, inclusive, são essenciais para o bom funcionamento de nossa microbiota. Porém, a pequena parcela que é, de fato, capaz de causar doenças tem gerado preocupação entre os especialistas. O motivo: aumento da resistência bacteriana aos antibióticos.
É neste contexto que a professora Regina Lúcia Baldini desenvolveu a linha de pesquisa de seu laboratório. Docente do Departamento de Bioquímica no IQUSP, ela está interessada em investigar e entender as estratégias de adaptação da bactéria Pseudomonas aeruginosa. Os estudos de seu grupo sobre a Pseudomonas começaram ainda em 2005, como parte do projeto Jovem Pesquisador da FAPESP. Na época, os pesquisadores buscavam compreender a regulação de genes localizados no interior da ilha de patogenicidade — região do genoma responsável por determinar a virulência da bactéria, a depender de sua composição especí ca em cada organismo.

Regina explica que a ilha de patogenicidade da Pseudomonas deve ter sido adquirida por transferência horizontal, isto é, vinda de uma outra bactéria. Isto porque essa não é uma região presente em todas as espécies de Pseudomonas.
“Ela tem algumas ‘dicas’ nessa região que mostram que ela foi adquirida como mosaico, vários pedacinhos diferentes. Então, a gente trabalhava com alguns genes regulatórios e, ao lado deles, genes de fímbria — apêndices da bactéria que servem para adesão ao substrato ou para adesão célula-célula”
Atualmente, o foco do Laboratório de Sistemas de Sinalização em Bactérias é o nucleotídeo C-di GMP — segundo mensageiro produzido em resposta a sinais internos e externos da bactéria. O C-di GMP é um elemento determinante para de nir se o modo de vida da bactéria será xo ou móvel — daí a importância de estudá-lo. Quando a bactéria tem baixos níveis intracelulares de C-di GMP, ela ca mais móvel. Já na formação de uma estrutura xa e mais resistente aos antibióticos, como é o caso do bio lme, os níveis de C-di GMP aumentam.
 Fórmula estrutural do Cyclic-di-GMP
Fórmula estrutural do Cyclic-di-GMP
A professora destaca ainda a necessidade de olhar não só para a concentração de C-di GMP, mas também para suas proteínas-alvo na bactéria.
“Como tem muitas proteínas que sintetizam, degradam ou ligam C-di GMP, estamos tentando descobrir a função de algumas delas que não foram estudadas ainda. Achamos que talvez essas proteínas que produzem o C-di GMP, chamadas de guanilato ciclases, atuem próximo a outra proteína que seja alvo dela. E isso vai mudar o microambiente dentro da bactéria”, comenta.
Em um de seus últimos trabalhos publicados, o grupo mostrou que uma das proteínas sintetizadoras de C-di GMP, a FimV, depende de outra proteína que faz parte do pili bacteriano — estrutura essencial para a mobilidade da bactéria em twitching. A professora explica: “quando a bactéria se liga ao substrato para formar as microcolônias e começar o bio lme, ela depende de outras fímbrias ou pili do tipo 4 — uma grande estrutura de proteínas diferentes que vão fazer esse pili sair e voltar da célula. Quando sai, ele pode se ligar ao substrato e, ao ser despolimerizado, desloca a bactéria, como se fosse uma lagartinha”.
O objetivo da pesquisa é entender melhor como funciona esse processo de locomoção, que ocorre ainda no início de formação do bio lme. Entre as metodologias do grupo, utiliza-se abordagens da bioquímica, microbiologia e biologia molecular.
“Estamos com alunos estudando essa proteína, fazendo a expressão, queremos puri car, estudar a atividade enzimática dela em mais detalhes e saber se tem outras proteínas que a gente sabe que fazem parte desse sistema envolvido com twitching”, completa.





A escolha da bactéria Pseudomonas aeruginosa para investigar o fenômeno de resistência aos antibióticos vem do seu alto potencial de adaptação ao ambiente, além de esta espécie estar relacionada a inúmeros casos de infecções crônicas. Regina explica que trata-se de uma bactéria que geralmente não causa doenças em pessoas saudáveis, mas que o quadro muda de gura nos casos de pessoas imunocomprometidas, com queimaduras ou feridas cirúrgicas, por exemplo. E chama atenção também para os pacientes com brose cística, uma síndrome genética em que a Pseudomonas encontra condições favoráveis para estabelecer uma infecção crônica.
A brose cística já foi tema do lme estadunidense “A Cinco Passos de Você” (Five Feet Apart, 2019), no qual os protagonistas Will e Stella vivenciam um romance hospitalar pautado pelas di culdades impostas por esta doença. Como retratado no longa, um dos principais problemas da brose cística está na retirada do muco do pulmão do paciente. “O muco é mais viçoso e é difícil de soltá-lo. Então, a bactéria coloniza e ela ca muito confortável no pulmão das pessoas que têm brose cística. A resposta imune do paciente, além de atacar a bactéria, ataca também o pulmão, então isso é um grande problema”, diz Regina Baldini. “No nal do lme, a menina vai fazer um transplante de pulmão. Nos Estados Unidos existe uma fundação de brose cística que tem muita pesquisa, que nancia vários grupos que pesquisam a Pseudomonas e outras bactérias”, completa.
Outra característica da Pseudomonas aeruginosa que merece destaque relaciona-se às suas formas de adesão, pois isto in uencia na maneira com que a bactéria se protege. “A adesão é importante, porque é como se a bactéria tivesse dois modos de vida: um livre e outro xo. Quando ela encontra uma superfície, ela sofre um processo de diferenciação — que faz com que ela se agrupe no que chamamos de microcolônias e forme um bio lme, estrutura onde as bactérias não se movem e secretam substâncias extracelulares que as protegem do ambiente externo”.
Desa os do bio lme e outros mecanismos de resistência bacteriana
Os bio lmes microbianos estão para as bactérias tal qual as capas estão para os super-heróis. O bio lme nada mais é do que um conjunto de células com substâncias poliméricas — as quais favorecem a aderência a superfícies bióticas e abióticas e são produzidas pelo próprio microrganismo, a m de que se aumentem as suas chances de sobreviver em um determinado meio. Ou seja, ele representa um tipo de proteção para os organismos que o produzem. Isto não signi ca, no entanto, que o bio lme seja bené co à saúde humana. Mais de 80% dos casos de infecções bacterianas em humanos estão associadas à formação de bio lmes. E justamente essa “capa” acaba sendo um dos principais desa os das ciências biológicas modernas ao di cultar a ação dos antibióticos, como no caso da P. aeruginosa.

A professora do Departamento de Bioquímica explica que quando as bactérias começam a crescer em bio lme, elas entram em um estágio siológico menos suscetível aos antibióticos. “A bactéria já tem vários sistemas de resistência a antibióticos, em qualquer um dos meios de vida dela. Mas, quando ela está em um bio lme, ela ca mais resistente ainda”. Logo, apesar de sua importância para a sobrevivência do microrganismo, o bio lme não faz todo o trabalho sozinho. Entre os mecanismos de resistência das bactérias aos antibióticos estão a atuação da membrana, bombas de e uxo, genes de resistência ou mutações.
No caso da Pseudomonas, estes fatores possuem certas especi cidades. Por ser uma bactéria Gram-negativa, ela possui duas membranas, uma interna e outra externa. Regina explica: “na maioria das bactérias, essa membrana externa tem poros por onde vão passar os nutrientes e vários compostos de maneira meio inespecí ca. Já na Pseudomonas, elas têm poros muito especí cos para substâncias que podem entrar ou não”.
Com essa dinâmica, os antibióticos di cilmente conseguem passar pela membrana. Mas, caso passem, existem ainda as chamadas bombas de e uxo — que estão situadas na membrana interna e são responsáveis por expulsar um determinado fármaco ou substância da bactéria. Isso resulta em um menor acúmulo intracelular dos antibióticos.
“A Pseudomonas tem uma lista de determinantes que fazem com que ela seja muito resistente. E quando ela está em bio lme, ela está em uma fase em que se divide menos, não está crescendo exponencialmente. Alguns antibióticos vão agir justamente quando essa bactéria está crescendo e se dividindo; se ela não está crescendo e nem se dividindo, ela não vai morrer por conta da presença desse antibiótico”, completa.
A competição entre bactérias no organismo faz com que a Pseudomonas não seja parte muito comum do microbioma humano. Contudo, quando em um ambiente hospitalar, onde se tem o uso de antibióticos para um determinado tratamento, a microbiota do paciente é prejudicada — o que acaba facilitando a infecção por Pseudomonas. “Quando falamos de resistência a antibióticos, temos que ter em mente a questão ecológica e evolutiva. A bactéria não ca resistente porque a humanidade começou a produzir antibióticos na década de 40, ela já era resistente, nós só estamos selecionando”, destaca Baldini.
Sobre a professora

Regina Baldini é professora do Departamento de Bioquímica e a temática de sua linha de pesquisa é Sistema de Sinalização em Bactérias.

O foco do grupo é compreender os mecanismos de adaptação e virulência de bactérias, em especial a Pseudomonas aeruginosa.
Mais informações em baldini@iq.usp.br.
bactérias
antibiótico


alo de inibicão i

A história do homem que não tinha cheiro: ‘O Perfume’ é um romance alemão que narra a trajetória do perfumista Jean-Baptiste Grenouille em busca da essência perfeita. Da cção à realidade, a atração por bons aromas é uma característica humana. Os cheiros despertam mais do que o simples reconhecimento de uma or ou fruta, de uma situação agradável ou perigosa. Um exemplo disso são as memórias, resgatadas na mente a partir do cheiro de um bolo ou de um perfume. Apesar do destaque para o prazer no aroma das essências, entretanto, esta não é a sua única aplicabilidade.

O Laboratório de Produtos Naturais
Bioativos do Instituto de Química da USP (IQUSP) desenvolve pesquisas que buscam compreender as aplicações terapêuticas e cosméticas de substâncias naturais encontradas em espécies nativas da Mata Atlântica Paulista. O foco principal do grupo é explorar as possibilidades de usos desses extratos como ativos com ação antifúngica e antibacteriana.
A proposta de pesquisa iniciou-se em 2004, com a participação de colaboradores do próprio IQ; Massayoshi Yoshida, da UFRGS; Amélia T. Henriques, Elfriedes E. S. Schapoval e Renata P. Limberger, do Instituto de Botânica; Maria Cláudia M. Young e Inês Cordeiro — que contaram com a coordenação de Paulo Roberto Hrihorowitsch Moreno, professor do Departamento de Química Fundamental do Instituto. Apesar da fase nanciada do projeto já estar concluída, os interesses em desvendar a aplicabilidade dos óleos essenciais continuam presentes no laboratório.
Entre as plantas escolhidas para estudo estão espécies das famílias da Lauraceae e Myrtaceae, ambas conhecidas pela produção de óleos voláteis. As Lauraceae também geram madeira de qualidade, como a imbuia, e frutos comestíveis, como o abacate. Dos 30 gêneros desta família, 16 ainda estão presentes nos remanescentes da Mata Atlântica. Já a Myrtaceae é reconhecida por seus frutos comestíveis, como a pitanga e a jabuticaba, e por ser uma das famílias com diversidade mais representativa — dos 130 gêneros, 24 estão no Brasil e a Mata Atlântica é onde se localizam as maiores riquezas.
A busca pelo aroma: da en eurage à destilação
A técnica utilizada para extrair óleos aromáticos de plantas não é nova. A en eurage, nome popular do processo, foi descrita pela primeira vez na França do século XVIII, para uso na perfumaria. Nela, as plantas eram embebidas em gordura animal ou vegetal em um processo lento, para que a fragrância da matéria-prima fosse absorvida pelo óleo até que ele casse saturado. Essa técnica já foi muito utilizada na fabricação de perfumes, para a extração de óleos essenciais a partir de pétalas de ores.
No laboratório, a técnica adotada para o isolamento dos óleos essenciais é a destilação a vapor com aparelho de Clevenger.
Neste processo, a água e o óleo se destilam juntos e, ao passarem pelo condensador, tornam-se líquidos novamente. Uma vez que a água e o óleo não se misturam, o óleo essencial pode ser facilmente separado. É um processo lento e de baixo rendimento, segundo o professor Moreno — a Farmacopéia Brasileira, por exemplo, estipula 4 horas de destilação para que se possa ter uma quantidade razoável do óleo essencial.

O cenário é corriqueiro: você provavelmente já deve ter ouvido que não se deve colocar o dedo dentro de um pote de creme — por isso, alguns deles são comercializados com uma espátula própria para a aplicação. Isso acontece, porque nossos dedos contêm microrganismos que, em contato com o produto, acabam diminuindo sua validade ao propiciar a proliferação de fungos, por exemplo.
Para resolver este problema, são adicionados conservantes ao cosmético, geralmente arti ciais, a m de evitar ou prevenir a proliferação de microrganismos e garantir a sua integridade. Na maioria dos casos, esses conservantes arti ciais são os parabenos, por terem uma atuação e caz em uma ampla variação de pH. O problema é que, apesar de sua atestada e ciência, estudos sobre toxicidade mostram que os parabenos podem ser acumulados intactos nos tecidos do corpo humano, tanto a longo prazo como em baixas exposições, além de estarem associados a quadros de alergia e serem prejudiciais à fertilidade.
Outra consideração feita em relação aos produtos artificiais é sobre a sua receptividade pelo público consumidor, como comenta
CristinaMaira Turim , mestre em farmacologia e medicamentos pela USP.
Como alternativa a esse problema, há os próprios óleos essenciais. “Podemos pensar [o uso dos óleos essenciais] em perfumaria pela parte prazerosa do cheiro ou como uma parte funcional dentro do cosmético, como a própria ação antimicrobiana. E por que se quer uma ação antimicrobiana em um cosmético? Porque dentro do próprio cosmético, esse óleo pode ter uma ação ativa de conservante”, explica o professor Paulo Moreno.
Isto é o que foi descrito recentemente por Cristina em sua dissertação de mestrado. Na pesquisa, ela avaliou a ação antibacteriana e antifúngica do óleo essencial da Pataqueira (Conobea scoparioides) — erva típica da Amazônia que ocorre nas 5 regiões brasileiras — em resposta a testes feitos com seis microrganismos, entre bactérias e fungos. Os resultados do estudo con rmaram a ação antibacteriana do óleo essencial da Pataqueira tanto em sua ação isolada quanto combinada a conservantes arti ciais.
Foto por A.V. Scatigna (2012) [ref. DOL43051]“A busca por produtos naturais é crescente. De um tempo para cá, o consumidor está mais exigente e está mais cauteloso na busca por um produto com menos ativos químicos artificiais e mais ativos naturais. Acho que isso é uma tendência”
“A ideia foi colocar esse óleo essencial junto a dois conservantes sintéticos, que seriam o metilparabeno e o propilparabeno, nas mínimas concentrações de cada um. E então, veri car se nós conseguimos diminuir a concentração desses conservantes sintéticos utilizando um óleo essencial, que seria um conservante de origem natural”, descreve a pesquisadora.
Ao todo, foram realizadas 10 combinações, que variavam a concentração do óleo essencial e dos conservantes sintéticos. Por m, com a utilização de um modelo estatístico, foi possível obter a melhor associação, dentre as testadas, para ser introduzida em uma emulsão cosmética.
“Essa formulação foi desa ada com os microrganismos e observou-se que houve um declínio de todos os seis. Isso provou que a associação do óleo essencial com os conservantes sintéticos teve uma boa resposta — o que diminui a quantidade dos conservantes sintéticos que podem provocar algum tipo de reação alérgica com o uso exacerbado. A ideia seria possibilitar a produção de um conservante ‘mais natural’”, diz Turim.
Estudos como o de Cristina são um exemplo de como as aplicações dos óleos essenciais podem abranger um cenário maior do que seu uso mais popular, que é o aromático. “A gente está em um país que é muito rico, que tem muita biodiversidade. Acho que ainda estamos engatinhando e nossa intenção é que isso seja explorado cada vez mais. É muito legal você usar algo que era aplicado em banho de cheiro, cura do beri-beri, e que agora estamos vendo uma outra função. Não é só a Conobea scoparioides, acho que existem óleos essenciais de outras plantas
que também vão promover isso. Então, eu acredito que é extremamente importante e pouco explorado”, comenta ela.

Entre as preocupações do setor industrial de bioprodutos está a manutenção da cadeia produtiva. Quando consideramos que parte primordial da matéria-prima para que se tenha um fármaco ou cosmético seja de origem vegetal, é preciso levar em consideração que essas espécies não serão extraídas de seu bioma sem restrições, a m de atender à demanda industrial. É aí que se encontra o dilema do setor: adaptar as condições de produção a uma dinâmica que substitua a extração pelo cultivo.
Para as pesquisas que são focadas na área de biotecnologia, a missão é tentar replicar o que se tem em condições naturais para o sistema de cultivo, sem que se altere o germoplasma — material genético de uma espécie, essencial para a viabilidade do cultivo comercial. Isso é feito para que se evite as consequências diretas do extrativismo em escala industrial: poluição do solo, desbalanceamento do ecossistema local e extinção de espécies, por exemplo.
Apesar dos baixos índices de desmatamento da Mata Atlântica Paulista mantidos entre 2011 e 2019, houve uma mudança a partir de 2020 — quando é possível notar que o desmatamento em hectares vem crescendo. É o que aponta o portal “Aqui tem Mata? ”: o índice saiu de 8 hectares em 2020 para 29 hectares desmatados no ano de 2021; tamanho equivalente a 41 campos de futebol.
Avanço do desmatamento na Mata Atlântica Paulista
Em um cenário como este, pesquisas que envolvem espécies nativas da Mata Atlântica Paulista desempenham um papel relevante para a sua preservação — principalmente no caso de estudos em que se busca conservar as características genéticas de uma espécie, para que se possibilite uma produção que não seja baseada no extrativismo.
“Apesar de estudarmos uma das famílias mais abundantes na Mata Atlântica, que são a Lauraceae e a Myrtaceae, a maioria de suas espécies não foi estudada ainda e não se conhece a composição química de seus óleos essenciais. Então, quando não se conhece uma coisa, é fácil dizer que não serve para nada. No momento em que você começa a ter um conhecimento e a formar um valor agregado naquilo, as pessoas querem preservar mais”, comenta o professor.

A m de descobrir outras ações terapêuticas dos óleos essenciais, Paulo Moreno explica que o próximo foco do laboratório é desenvolver as abordagens acerca da atuação desses óleos na fase vapor, para a descontaminação de ambientes. Este tema faz parte da pesquisa de seu aluno de doutorado Marcos A. A. Pereira, sobre a atividade antimicrobiana a vapor do óleo essencial de Hesperozygis myrtoides, conhecido como Poejo.
“Esse óleo poderia ser utilizado da mesma forma que os difusores de óleo essencial de ambientes, para diminuir a carga microbiana do ambiente. Então, o objetivo da pesquisa do Marcos é desenvolver um método para medir essa atividade antimicrobiana na fase vapor — e ele usou a Hesperozygis myrtoides como modelo”, explica o professor. Para comparar a ação antimicrobiana do óleo essencial, ele foi testado em solução em um meio de cultura líquido e a ação de seus vapores em um meio de cultura semi-sólido. Como resultado, observou-se que ele é mais ativo na fase vapor — isto é, sua ação antimicrobiana mostrou-se mais intensa neste caso.
“Então, temos buscado pesquisar a ação antimicrobiana dos óleos essenciais na fase de vapor, pensando nessa parte de descontaminação de ambientes”, completa.
Sobre o professor:
Paulo Roberto Hrihorowitsch Moreno é docente do IQUSP desde 1997 e atua no Departamento de Química Fundamental. Sua linha de pesquisa é focada em Produtos Naturais Bioativos. Com ênfase em farmacognosia, seu laboratório busca compreender as aplicações terapêuticas de substâncias naturais.
Para mais informações: prmoreno@iq.usp.br
Faleceu no dia 29 de maio de 2022 o Prof. Dr. Paulo Marques, deixando um grande vazio para seus familiares e amigos, dentre os quais eu me incluo. Foi sempre uma pessoa de interesses múltiplos, atuando nas áreas de jornalismo, comunicação social e divulgação cientí ca, entre outras. Teve sempre uma ligação muito estreita com a Universidade de São Paulo (USP), onde se doutorou sob orientação do saudoso Prof. Shozo Motoyama, na área de História da Ciência.
Como jornalista, atuou na Folha de São Paulo, Jornal do Brasil, Jornal do CHC e no nosso Jornal Alquimista, entre outros periódicos de destaque, o que lhe possibilitou viajar extensivamente pelo país e exterior. Na USP, atuou durante vários anos na área de comunicação social, durante a gestão de diversos reitores. Uma de suas características era a formação abrangente, que lhe possibilitava discutir com profundidade sobre temas cientí cos, políticos e religiosos. Não se considerava um erudito, mas admirava a erudição. Sempre foi um leitor voraz dos grandes clássicos da literatura nacional e estrangeira. Tinha por Bach uma veneração quase religiosa.
Desde jovem, Paulo foi um revoltado contra as injustiças sociais, que afrontavam seus princípios éticos. Isso o conduziu a uma atuação política destacada durante a ditadura militar, o que trouxe consequências dramáticas para a sua vida pessoal. Neste período, chegou a ser preso e exilado no Chile, Argélia e França. Um rebelde, mas nunca um radical, pois sabia analisar as enormes injustiças sociais do país com um olhar abrangente, muito além do ideológico. Escreveu inúmeros textos de divulgação cientí ca na área de astronomia e de energia nuclear. No lado pessoal, foi sempre o amigo certo das horas incertas. Nos últimos anos, sua saúde foi progressivamente se deteriorando, mas a dedicação de sua irmã possibilitou que pudéssemos usufruir de sua companhia por mais alguns preciosos momentos. Foi-se um intelectual e rebelde com causa, mas seus exemplos de ética e dignidade permanecem, tão necessários nos dias atuais.
Vale ressaltar que o Prof. Paulo Marques contribuiu efetivamente por mais de 10 anos como Editor do Jornal Alquimista do IQUSP e, portanto, somos muito gratos a ele pela excelente colaboração.
 Prof. Dr. Paulo Sérgio Santos
Prof. Dr. Paulo Sérgio Santos




Pesquisadores do IQUSP desenvolvem composto antiviral e caz no combate ao novo coronavírus
Um dos principais feitos do IQUSP durante a pandemia foi o desenvolvimento de um composto antiviral utilizado em máscaras e outros produtos — como cremes, enxaguantes bucais e etc. — para combater a transmissão do coronavírus (Sars-CoV-2). O grupo responsável por esta invenção pertence ao Laboratório de Química Supramolecular e Nanotecnologia do IQUSP, coordenado pelo professor Koiti Araki.
A molécula, derivada do corante ftalocianina, liga-se ao oxigênio presente no ar e torna-o mais ativo, de modo a provocar danos oxidativos nas partículas virais. Posteriormente, ela foi testada em culturas de células infectadas com o Sars-CoV-2 e com o vírus da In uenza, onde comprovou-se uma e cácia de 99,96% em reduzir a carga viral sem provocar efeitos citotóxicos ou alterações metabólicas celulares.

Com o sucesso do composto e otimizações em seu processo produtivo, uma parceria entre o IQUSP, ICB e a empresa Golden Technology permitiu a sua fabricação em larga escala, bem como o uso em produtos comerciais como as máscaras faciais (Phitta Mask) ou enxaguantes bucais, entre outros.
Hernan Chaimovich Guralnik e Walter Colli são homenageados com o título de professores eméritos
Em 13 de maio de 2020, o já Professor Emérito do Instituto de Química e Colaborador Sênior do Departamento de Bioquímica, Hernan C. Guralnik, recebeu o título de Pesquisador Emérito do CNPq, em reconhecimento ao conjunto de sua obra cientí co-tecnológica e por seu renome junto à comunidade acadêmica. A cerimônia de entrega foi realizada no Rio de Janeiro e contou com a participação do Ministro da Ciência, Tecnologia, Inovações e Comunicações e do Presidente do CNPq. Além de Hernan, a honraria já foi concedida a mais de 50 pesquisadores desde a sua instituição, em 2005.
Já em 2021, no dia 10 de agosto, o agraciado foi o também Professor Emérito do IQ Walter Colli, que recebeu na ocasião o título de Professor Emérito da USP. Este título é concedido a professores aposentados que se distinguiram por atividades didáticas e de pesquisa ou que tenham contribuído, de modo notável, para o progresso da Universidade.
https://pesquisaparainovacao.fapesp.br/mascara_antiviral_desenvolvida_pela_usp_e_empresa_pode_ser_usada_por_12_horas/1588
https://g1.globo.com/sp/sao-paulo/noticia/2022/06/12/mascara-desenvolvida-pela-usp-contra-covid-19-inativa-tambem-virus-da-gripe.ghtml
https://veja.abril.com.br/saude/usp-consegue-desenvolver-em-escala-molecula-que-inativa-novo-coronavirus/
Fontes: Pesquisa para Inovação – FAPESP, G1 e Revista Veja.
Desde a sua fundação, em 1934, foram outorgados somente 20 títulos a docentes da instituição. A cerimônia de entrega foi realizada na Sala do Conselho Universitário e contou com a participação do reitor da USP, Vahan Agopyan, além de dois outros homenageados, entre outros convidados: os professores Antonio Candido de Mello e Souza, da Faculdade de Filoso a, Letras e Ciências Humanas (FFLCH), e Erney Felício Plessmann de Camargo, do Instituto de Ciências Biomédicas (ICB).
https://jornal.usp.br/institucional/walter-colli-recebe-o-titulo-de-professor-emerito-da-usp/
Fonte: Jornal da USP

A pandemia de COVID-19 também foi um momento propício para muitos pro ssionais desenvolverem e tirarem do papel seus projetos pessoais. Neste sentido, alguns docentes do IQUSP escreveram ou contribuíram com livros publicados durante esse período que merecem o nosso destaque:
https://www.edusp.com.br/livros/quimica-de-coordenacao/

A química de coordenação focaliza os elementos metálicos e seus compostos, de modo a permear diversas áreas do conhecimento.
De autoria dos professores Ana Maria da Costa Ferreira e Henrique Eisi Toma, a obra mostra na prática como lidar com estes elementos e seus ligantes.

https://materiais.smbrasil.com.br/sm-lp-atlas-molecular-de-sustentabilidade-duplicado

Voltado ao sistema básico de ensino, o livro eletrônico reúne informações sobre substâncias e materiais com destacada relevância para a consecução dos Objetivos de Desenvolvimento Sustentável (ODS). Cada capítulo versa sobre uma substância ou material especí co, que é tratado em seus aspectos cientí cos, sociais, econômicos e ambientais. Os responsáveis por esta publicação são o professor Guilherme Marson (IQUSP) e os alunos Leila Teruya, Ellen Maria da Silva e Júlio Vieira.
https://www.amazon.com/Where-Does-All-That-Food-dp3030509672/dp/3030509672/ref=mt_other?_encoding=UTF8&me=&qid=159769314

O livro discorre sobre o que é o metabolismo, como se organizam as reações químicas que o compõem, como ele é regulado e qual a sua importância para a manutenção da vida. A autoria é de Alicia Kowaltowski (IQUSP) e Fernando Abdulkader (ICB).
https://www.blucher.com.br/purificacao-de-produtos-biotecnologicos_9788521219460

Esta publicação tem como público-alvo os graduandos em Engenharia Química e de Alimentos, bem como áreas correlatas. Com 22 capítulos, o livro aborda de maneira didática as operações unitárias que compõem os processos empregados no isolamento de biomoléculas, tanto na escala industrial quanto laboratorial. O grupo de pesquisa do Laboratório de Química de Peptídeos contribuiu com o capítulo 21 (Prof.ª Maria Teresa Machini & Cleber Wanderlei Liria), intitulado “Fundamentos para produção, puri cação e caracterização de peptídeos de interesse biotecnológico” (701-727).
https://jornal.usp.br/wp-content/uploads/2022/10/Lista-Cientistas-mais-Influentes-2021.pdf

https://www.iq.usp.br/portaliqusp/?q=pt-br/node/1297
https://jornal.usp.br/institucional/247-pesquisadores-da-usp-estao-entre-os-mais-influentes-da-ciencia-mundial/
https://www.iq.usp.br/portaliqusp/?q=pt-br/node/1297


https://jornal.usp.br/ciencias/cientistas-identificam-genes-associados-a-proliferacao-de-tumores-do-cancer-de-pancreas/
Química do “clique” ganha o prêmio Nobel de 2022
https://jornal.usp.br/ciencias/quimica-do-clique-ganha-o-premio-nobel-de-2022-tecnica-e-aplicada-em-pesquisas-na
Jornal da USP
O método, que resulta na simplicidade e funcionalidade na construção de moléculas, faz parte das pesquisas do grupo da professora Sayuri Miyamoto, do Departamento de Bioquímica do IQUSP. Seu objetivo é compreender quais reações no cérebro podem favorecer o aparecimento de doenças neurodegenerativas.
https://agencia.fapesp.br/apesar-de-benefica-para-a-maioria-dos-orgaos-restricao-calorica-pode-causar-danos-aos-rins/38797/
Estudo revela mecanismo pelo qual o ácido úrico causa dano vascular
http://redoxoma.iq.usp.br/
Liderados pela professora Flavia Carla Meotti, do IQUSP, os pesquisadores mostraram que o ácido úrico é oxidado pela enzima peroxidasina em células endoteliais, prejudicando a formação da matriz extracelular e causando a diminuição da adesão e migração dessas células. Os resultados do estudo foram publicados na revista cientí ca Antioxidants.
https://agencia.fapesp.br/metodologia-de-triagem-virtual-permite-a-descoberta-de-potenciais-compostos-anti-inflamatorios/38413/
http://redoxoma.iq.usp.br/


https://pubs.acs.org/doi/10.1021/acs.jcim.0c00813https://pubs.acs.org/doi/10.1021/acs.jcim.0c00813
https://pubs.acs.org/doi/10.1021/acs.jcim.0c00813
https://pubs.acs.org/doi/10.1021/acs.jcim.0c00813https://pubs.acs.org/doi/10.1021/acs.jcim.0c00813
CEPID Redoxoma
Da Itália para os solos brasileiros. A correlação entre arquitetura e química, que à primeira vista pode parecer improvável, mostra parte daquilo que é um dos pilares presentes na trajetória do nosso professor biografado: a interdisciplinaridade.
Paolo Di Mascio, nascido em março de 1961 na região de Abruzzo, é professor do Departamento de Bioquímica, membro titular da Academia de Ciências do Estado de São Paulo e da Academia Brasileira de Ciências.
Com sua formação desde o primário até o superior dada em Bruxelas, na Bélgica, Di Mascio despertou seu olhar para a área cientí ca no início do curso superior de arquitetura.
“Me lembro que, quando fazia aula de arte, de desenho e de materiais e estava estudando resistência de materiais na arquitetura, tem sempre Química também, nos elementos que fazem parte dos materiais — como uma tinta, cimento, viga. A gente tinha aulas de ciência bastante pesadas e comecei a gostar também dessa parte”, relata ele.
A partir deste novo interesse, Paolo se formou posteriormente em Química Clínica na Université Libre de Bruxelles e em Tecnologia Biomédica pela Université Catholique de Louvain. Fez seu doutorado interuniversitário em Tecnologia Biomédica pela Faculté de Médecine da Université Catholique de Louvain, na Bélgica, e pela Universidade de Düsseldorf, na Alemanha.
Durante sua estadia na Alemanha, Paolo conheceu pesquisadores brasileiros e se interessou pelas pesquisas que estavam sendo desenvolvidas por aqui. Com isso, em 1988 ele vem para a USP, para trabalhar em seu doutorado com o apoio do professor Carlos Frederico Martins Menck, docente no Instituto de Ciências Biomédicas. Dois anos mais tarde, em 1990, com apoio do Banco Internacional de Desenvolvimento de Nova Iorque, Di Mascio passou a atuar no Brasil como pesquisador convidado do CNPq, concluindo seu pós-doutorado em 1994 pela USP.

Além de Proust, na lista de favoritos estão os poetas Alphonse de LaMartine e Paul Verlaine, além das peças “Cyrano de Bergerac”, de Edmond Rostand, e “O Doente Imaginário”, de Molière. A dramaturgia não aparece somente nas leituras do professor: entre os vários trabalhos que chegou a desempenhar durante a graduação — como em restaurantes, construções e hospitais — estava o Teatro. Se aos sábados e domingos, em Bruxelas, o público via uma peça de Molière acontecer, era também porque Paolo participava dos bastidores de produção, cuidando de assuntos diversos como entrada, abertura e palco.




Voltando à vida acadêmica, entre os nomes que inspiram e são referência para Di Mascio estão Annie Ernaux, escritora francesa Nobel de Literatura; Jacques Monod, bioquímico francês Nobel de Fisiologia, que junto a André Lwo tt trabalhou o conceito de sítios regulatórios de ácido desoxirribonucléico (DNA) e introduziu na genética o conceito de ácido ribonucléico (RNA); e Christian De Duve, bioquímico Nobel de Medicina por seu trabalho sobre a estrutura e o funcionamento celular. De Duve também foi professor de biologia celular de Paolo — que, por sua vez, relembra a admiração pela forma especial como ele tratava o ensino para os jovens.




A linha de pesquisa de Paolo na Bioquímica se caracteriza principalmente pela atuação nos estudos de Arquitetura Molecular e Processos Redox — ou seja, na busca por compreender como os mecanismos de espécies reativas de oxigênio atuam siológica e pato siológicamente.
Fora da vida acadêmica de Paolo, que também atuou como diretor do IQ entre 2018 e 2022, estão atividades de áreas um tanto distintas entre si. O interesse na construção já vem da infância, com a produção de pequenos explosivos, por exemplo — uma atividade de lazer que ele fazia rotineiramente com o pai.

“Eu gosto de plantas, gosto da natureza, essas coisas de sítio; motor, mecânica, construção e de desenhar...”
Por m, entre os conselhos para os que estão chegando agora na vida acadêmica, Di Mascio recomenda procurar, dentro das possibilidades disponíveis, fazer o que se gosta.

Além disso, destaca a importância de não se fechar em seu próprio universo e estar aberto a buscar novos interesses, para que essa etapa ou futura trajetória na universidade não se resuma apenas à vida acadêmica e para que se construam novas formas de olhar para um mesmo objeto.
“Os alunos têm que garimpar, explorar os sites e buscar o que está acontecendo. Interagir com outras faculdades, outras pessoas que vão encontrar no Cepeusp, em uma peça de teatro. Vocês terminam [a graduação] em 4 anos, tem que buscar se divertir com consciência, fazer arte. Depois, vocês terão uma responsabilidade mais complexa. Tem que aproveitar isso. Gosto que meus alunos tenham uma visão mais ampla, de olhar em volta de quem está com eles e o que os colegas estão fazendo”.
Mais informações em pdmascio@iq.usp.br.

Meu nome é Bruna Larotonda, sou jornalista e biomédica formada na USP. Minha paixão é a divulgação cientí ca e meu objetivo pro ssional é levar a ciência e o conhecimento a todas as pessoas. Por isso, aceitei o desa o de liderar a nova equipe de Comunicação do IQUSP e estou muito empolgada nesta nova jornada!
Me chamo Daniel Kniss, tenho 21 anos, sou técnico em Petróleo e Gás (IFPR) e graduando em Ciências Sociais (USP). Adepto do estilo multitarefa e entusiasta da interdisciplinaridade, colaboro com o setor visual do setor de Comunicação, com o objetivo de dar moldes grá cos compatíveis com a excelência do IQ.
Meu nome é Aldrey Olegario, tenho 20 anos, sou de Piracicaba e estagio no novo setor de Comunicação do IQ. Estou no 3º ano de graduação em jornalismo na ECA/USP e parte do interesse em participar deste projeto veio de uma disciplina laboratório que me chamou a atenção para a área de divulgação cientí ca.
Meu nome é Lara Ribeiro, tenho 18 anos e estou no primeiro ano de graduação em Química. Gosto muito de divulgação cientí ca e mídias sociais e tenho me apaixonado cada vez mais por esse trabalho. Estou aprendendo sobre a parte grá ca e de design, além de ajudar nas atividades do setor de Comunicação.





Onde a comunidade do IQ expõe sua veia artística











Onde a comunidade do IQ expõe sua veia artística









Na cidade de Conquista, a em que cresci, as noites eram inquietas e de clima frio. Isso pelo menos nas ruas, mas se você olhasse por entre as janelas das grandes casas, podia-se sentir o caloroso poder que defendia os mais ricos da noite, a qual chegava a quase congelar os magrelos cães de rua e seus donos que, vira e mexe, morriam de hipotermia.
E eram multidões que caminhavam sem rumo por Conquista, desacompanhadas de empregos e banhos. Ignoradas totalmente pelas autoridades, as mazelas sofridas se tornam sujeira acumulada. E a sociedade higienista, ao invés de ajudar essas pessoas a limparem tamanhas impurezas da desigualdade, apenas as excluem, o que afunda tais pessoas cada vez mais nos ventos gelados de Conquista, cidade que só é boa para alguns.


Em meio às multidões, um homem, que diz se chamar Misericordioso. O migrante é rodeado de gente no dia, mas nas noites seu caminho se faz solitário até às 6 da manhã — a hora em que se retira para um barraco simples, construído por ele mesmo, localizado ao lado de um fedorento córrego. Este barraquinho era, visivelmente, construído por alguém que nem mesmo sabe o básico de proporção. Mas ele tentou reproduzir aquilo que vira feito nas casas de gente rica, na maioria branca, em construção. Observa construções o dia todo, sonha em ser construtor de grandes casas, para colocar um sorriso no rosto dos bem de vida que habitavam Conquista. Mas as casinhas que construiu para si provavam a ele que, antes de conseguir um emprego que permita-o construir casas para os outros, ele tinha que aprender a fazer isso.
Desta vez, a casa que construiu dura. Já vi-o chorar pela bola de demolição que, inúmeras vezes, derrubou sua casa a mandato da prefeitura de Conquista; eram tábuas e poucos tijolos descendo córrego abaixo. Ouvi que outra expedição de Conquista vai derrubar todas as casas que compreendem ocupação irregular — em uma destas moradias, encontra-se a de Misericordioso.
Pobre Misericordioso, cresceu já miserável. Quando pequeno, trabalhava com seu pai; eram bóias frias, praticamente escravos. Com o tempo, foi perdendo sua família. Restou apenas o homem que deixou de se cuidar, gostava de sonhar, mas a esperança, de sonhos um dia
realizar, saiu de sua mente como areia cai por entre os dedos. Como já disse, à noite ele anda sozinho — pelo menos, longe de gente. Misericordioso se despede dos amigos às 18 e vai para um bar, que ca aberto até às 19. Enche a cara. Como vai pagar é o que o homem nunca soube, mas necessita beber desesperadamente a aguardente que o consola; comida é muito mais cara. Morre de fome e cirrose um
Quando Misericordioso sai do bar, cambaleando, começa a perturbar o silêncio de Conquista, fede a álcool e carniça. Durante a noite, grita pelas ruas afora "Oh, peste!", repetidas vezes. Muitos acordavam e xingavam-no; eu, quando o ouvia, me incomodava, até entender que ele estava apenas pedindo ajuda, de seu jeito. Até eu ouvir ele contando sua história e se apresentando para alguém, o chamava de "Senhor das Pestes", pois as repetidas vezes tinham limite no in nito da escuridão de Passavam 12 horas desde o início da bebedeira, já estava sóbrio por essa hora. Agora, se via nos céus de Conquista os abutres de todas as manhãs, os quais seguiam Misericordioso. Isso não se sabe o motivo: seja por se verem no homem, em relação ao repúdio que a sociedade tinha por estes, ou por estarem esperando o último suspiro do indivíduo, para que pudessem se deliciar de sua carne já quase decomposta, mesmo que viva.

Pobre lho da sociedade de Conquista que, no mundo capitalista, afogou no córrego, o qual levava dejetos da ''população de bem'', vidas feitas na base de uma esperança primária que foi cortada pela miséria. E os esperançosos, torturados pela falta de emancipação e oportunidade.
Misericordioso foi encontrado morto pelo frio congelante de Conquista, após derrubarem sua casa. Não foi ao bar às 18, se deitou na beira do córrego; seu corpo não foi levado pela água poluída, a natureza fez questão de fazer um velório. Os ratos se reúnem em seu corpo, os abutres desceram em compaixão e fome. Aquela cena foi interrompida pela prefeitura: hoje, foi enterrado como indigente. Misericordioso, sem nome? Sem vontade? Sem justiça!